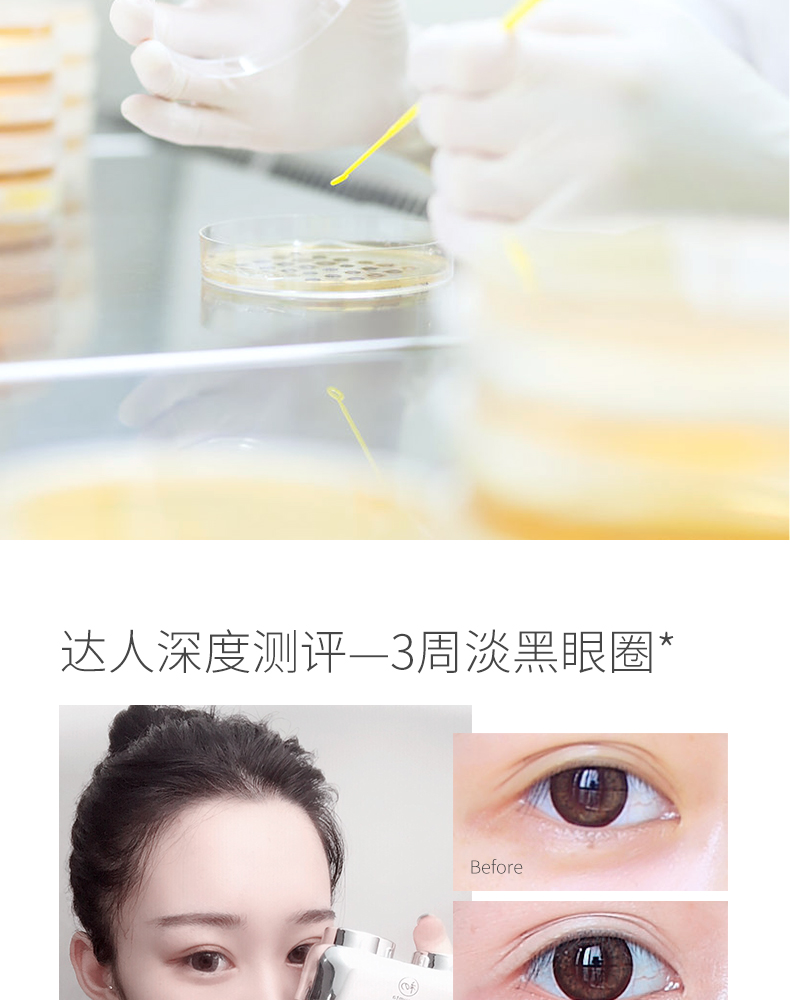

【淡化黑眼圈】多肽肌活日夜眼霜10g+10g 保湿修护 淡化黑眼圈 眼部细纹
¥39.90
限时折扣
原价:¥69.90
| 运费: | 免运费 |
| 库存: | 102 件 |
商品详情

- 初夏堂护肤旗舰店 (微信公众号认证)
- 萃取天然植物精华,专注于天然护肤,为你成就更美丽,更自信的自己。天然臻萃,之美如初。是我们所以一直坚持的新年。
- 扫描二维码,访问我们的微信店铺
- 随时随地的购物、客服咨询、查询订单和物流...